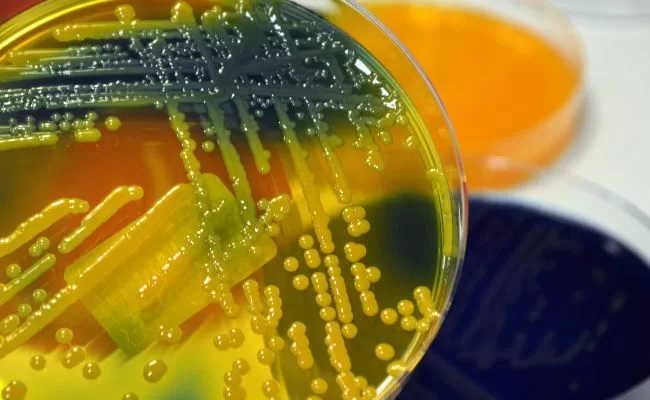
What Is A Biofilm and Why Should Ship Owners Take Care to Prevent It Occurring?

Crew Welware Posts
Please see Martek Marine’s latest news, guides and product-related information about crew welfare.
-

Why testing the safety of your water is helpful to the environment
-

Considerations When Buying an AED For Your Vessel
-

What Is A Biofilm and Why Should Ship Owners Take Care to Prevent It Occurring?
-

The risk of Legionella at sea
-

10 Reasons Why Access to Drinking Water is so Vital
-

The Most Common Cause of Death at Sea
-

Can I Be Held Liable For Using An AED?
-

Reduce your plastic waste with Drinksafe
-

Sir Ranulph Fiennes owes life to AED